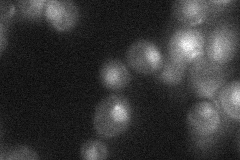
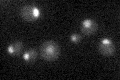

View description
Putative chaperone of the HSP40 (DNAJ) family; overexpression interferes with propagation of the [Psi+] prion; the authentic, non-tagged protein is detected in highly purified mitochondria in high-throughput studies
Localization:
Intensity:
Fold change:
Significance:
-
C’ GFP library in SD

nucleus20.87 -
N' NOP1pr-GFP in SD

punctate,nucleus54.5248 -
N' TEF2pr-mCherry in SD

punctate,nucleus47.4349 -
N' NATIVEpr-GFP in SD
nucleus24.6011 -
N' TEF2pr-VC and Cyto-VN in SD

nucleus26.1772 -
C’ GFP library in SD+DTT

nucleus21.91.04No -
C’ GFP library in SD+H2O2

nucleus19.680.94No -
C’ GFP library in Starvation Media
nucleus18.020.86No -
C’ GFP library on the background of Pup2-DaMP

nucleus -
C’ GFP library on the background of CCT mutant

nucleus20.08950.962201No
